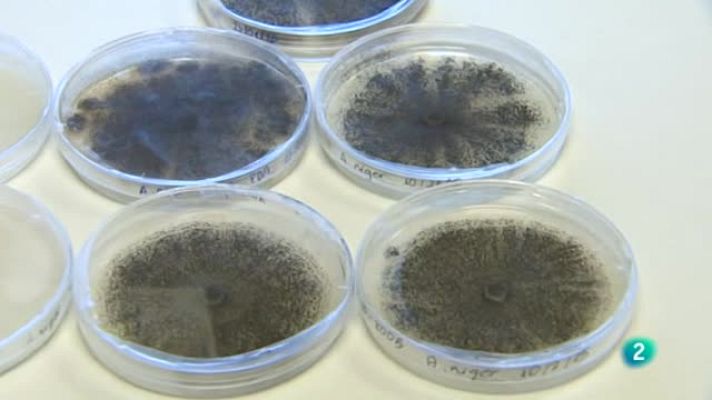
Agrosfera - Aspergilus

Agrosfera
Aspergilus
Investigadores de Valencia y Praga estudian alternativas naturales a los pesticidas. Aspiran a combatir las plagas con aceites esenciales de...
Disponible hasta: 27-02-2115
21/03/2015 00:01:50